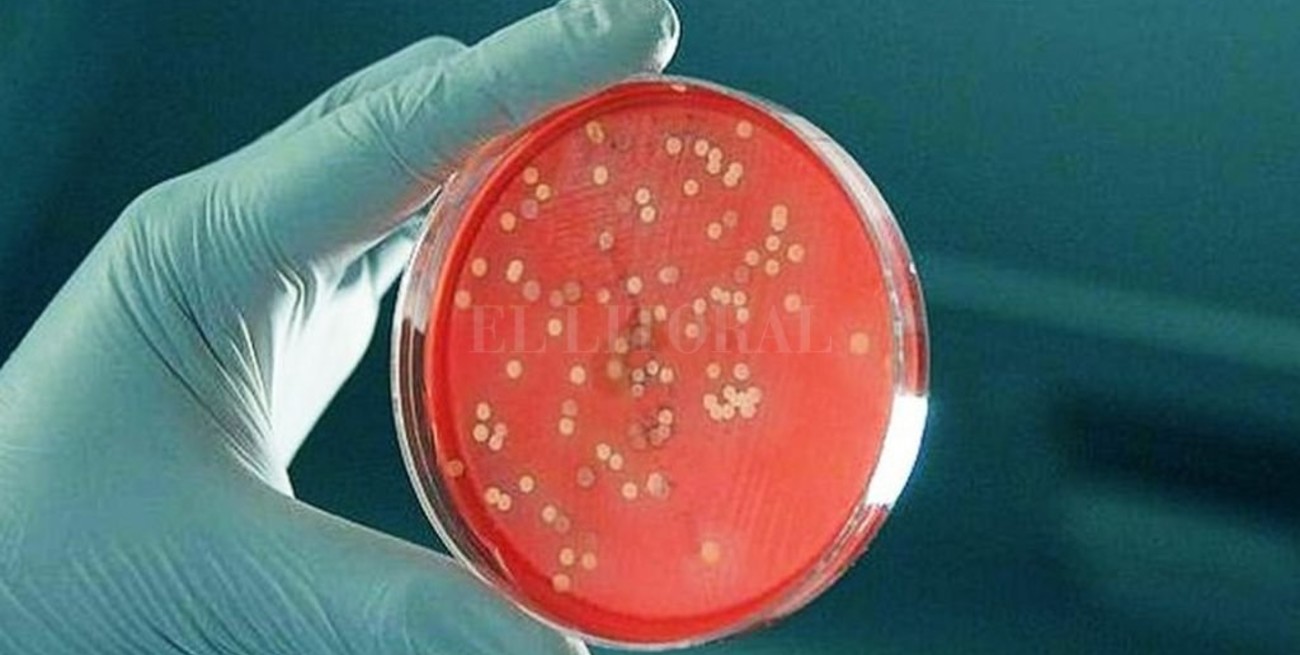

El Litoral | [email protected]
La bacteria es "conocida" y sensible a los antibióticos, confirmó el Malbrán
Los investigadores del instituto nacional analizaron cepas de los pacientes que sufrieron complicaciones graves en los últimos días. El análisis preliminar indicó que son los genotipos habituales y que no son resistentes a los antibióticos.

Los primeros análisis que se llevaron adelante en el Instituto Carlos Malbrán confirman dos puntos centrales: los genotipos de la bacteria streptococcus pyogenes que se estudiaron son sensibles a los antibióticos —no son resistentes, como otras bacterias— y circulan en el país desde hace años.
En un comunicado, la Administración Nacional de Laboratorios e Institutos de Salud “Dr. Carlos G. Malbrán” (Anlis) informó que se analizaron siete aislamientos de streptococcus beta hemolítcos, que corresponden a cuatro pacientes del Hospital Elizalde y a tres más que estuvieron internados en la Clínica Pergamino, en la Clínica Quilmes y en el Hospital Eva Perón de Rosario, el único caso fatal que se confirmó oficialmente en la provincia de Santa Fe. “Todos fueron confirmados como streptococcus pyogenes y resultaron sensibles a todos los antibióticos ensayados”, informó el laboratorio nacional de referencia.
Los investigadores realizaron subtipificación y genotipificación por secuenciación de genoma completo (WGS). De los siete aislamientos de la bacteria, seis corresponde al tipo emm1-secuenciotipo 28, que es el clon dominante en enfermedades invasivas alrededor del mundo y también en la Argentina. El otro aislamiento resultó un tipo emm 12 secuenciotipo 36, que si bien es menos prevalente también se encontraba circulando en el país.
Desde el Anlis explican que al tratarse de un clon que ya se encontraba circulando en el país, concluyen que la población ya ha estado en contacto con el mismo y desarrolló inmunidad protectiva, por lo cual no esperan un número de casos mayor al habitual.
“De cualquier forma, es importante aclarar que la vigilancia se encuentra activada y que se continúa con los estudios para detectar cambios genéticos que nos permitan predecir el impacto clínico de la infección por esta bacteria”, indica el comunicado.
La situación en Santa Fe
En una entrevista con El Litoral, Carolina Cudós, directora del área de Epidemiología del Ministerio de Salud, informó que no se reportaron nuevos casos fatales en la provincia —luego del de Rosario— y que la cantidad de pacientes afectados es la habitual en la provincia.
“Hay anginas por streptococcus como toda la vida, lo que si se incrementó un 1.000 por ciento es la cantidad de hisopados que se están haciendo en los hospitales y sanatorios por la demanda de la gente, ante el temor que genera la bacteria”, reconoció.
A nivel nacional, la muerte de un chico en Catamarca y la de un hombre de 77 años en Mar del Plata por streptococcus pyogenes elevó a nueve la cifra de víctimas fatales por esta bacteria. También se estudia el caso de un chico de dos años, a quien le habían diagnosticado una angina y luego falleció en Miami mientras estaba de vacaciones con su familia
En el mundo hay más casos graves
En las últimas décadas, se registró un incremento global de las infecciones invasivas por streptocuccus pyogenes en Europa y América del Norte. Lo reconoce un informe especial que elaboraron los epidemiólogos de la Secretaría de Salud de la Nación y los especialistas del Servicio de Bacteriología del Malbrán.
“En Estados Unidos, en población general, se estiman anualmente de 10.000 a 13.000 casos de infección severa o invasiva por streptococcus pyogenes, de los cuales alrededor de 1.600 fallecen por esta causa (letalidad 10%)”, precisa el informe, que se publicó en el último boletín de Vigilancia Epidemiológica.
El trabajo puntualiza que se trata de un evento estacional, que registra el 90% de los casos graves durante los meses de invierno e inicios de la primavera.
Signos de alarma
El estreptococo de grupo A (EGA) es una bacteria que se encuentra a menudo en la garganta y en la piel. La mayoría de las infecciones son relativamente leves, pero en ocasiones raras esta bacteria puede ocasionar otras enfermedades agudas más graves. Es muy importante consultar urgente si el paciente presenta:
- Fiebre con temblores.
- Palidez marcada o coloración azulada de labios y extremidades.
- Manchas rosadas violáceas en la piel.
- Dificultad para respirar que se incrementa
- Rechazo de líquidos y alimentos.
- Cuadros confusionales, sueño o irritabilidad excesiva.